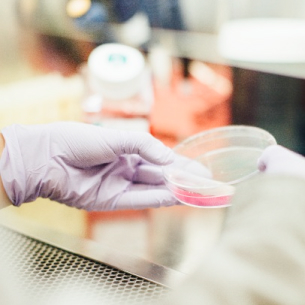

Research Studio supports healthcare entrepreneurship through training programs and startup support. We offer:

CIME
Center for Innovative Medicine and Engineering
CIME enables the future of healthcare through advanced scientific collaboration.

Business Strategies
Clinical Development and Business Management Program
Gain business expertise and insights in the medtech and biotech industries through case studies featuring new drugs and medical devices rollout.

Regulatory Science
Regulatory Science Program
Learn to navigate the regulatory pathway from scientific innovation to approved medical treatments through expert lectures on drug and device development.